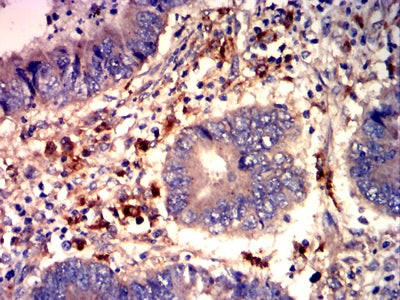
5

| 经过测试的应用 | |
| WB | WB-1/500 - 1/2000 |
| IHC | IHC-1/200-1/1000 |
| FCM | FCM-1/200-1/400 |
| ELISA | ELISA-1/10000 |
| 反应物种 | Human,Mouse |
| 抗体类型 | Primary antibody |
| 克隆性 | Monoclonal |
| 宿主 | Mouse IgG1 |
| 基因名 | OLR1 |
| 分子量 | 30.6 kDa |
| 形式 | Liquid |
| 存储缓冲液 | Purified antibody in PBS with 0.05% sodium azide and 50% glycerol. |
| 储存 | Store at 4°C short term. Aliquot and store at -20°C long term. Avoid freeze/thaw cycles. |

Black line: Control Antigen (100 ng);Purple line: Antigen (10ng); Blue line: Antigen (50 ng); Red line: Antigen (100 ng) Western blot analysis using OLR1 mouse mAb against Raji cell lysate
Western blot analysis using OLR1 mouse mAb against Raji cell lysate Flow cytometric analysis of Raji cells using OLR1 mouse mAb (green) and negative control (red)
Flow cytometric analysis of Raji cells using OLR1 mouse mAb (green) and negative control (red) Immunohistochemical analysis of paraffin-embedded human cervical cancer tissues using OLR1 mouse mAb with DAB staining
Immunohistochemical analysis of paraffin-embedded human cervical cancer tissues using OLR1 mouse mAb with DAB staining Immunohistochemical analysis of paraffin-embedded human rectal cancer tissues using OLR1 mouse mAb with DAB staining
Immunohistochemical analysis of paraffin-embedded human rectal cancer tissues using OLR1 mouse mAb with DAB staining
×